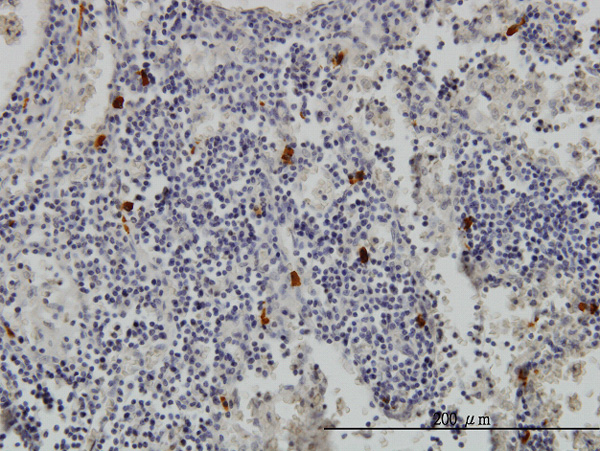

> Antigen, Antibodies, ELISA, Western Blot > Primary Antibody > Monoclonal Antibodies > TPSAB1 Antibody (monoclonal) (M01)Brand |
Leading Biology | Catalog Number |
APR10530G |
Product Type |
Monoclonal Antibodies | Field of Research |
|
Product Overview |
We constantly strive to ensure we provide our customers with the best antibodies. As a result of this work we offer this antibody in purified format.
We are in the process of updating our datasheets. If you have any questions regarding this update, please feel free to contact our technical support team.
This product is a high quality TPSAB1 antibody (monoclonal) (M01).
|
||
Molecular Weight |
30515 Da
|
||
Host |
mouse
|
||
Species Reactivity |
Human
|
||
Target |
TPSAB1 (AAH28059, 1 a.a. ~ 275 a.a) full-length recombinant protein with GST tag. MW of the GST tag alone is 26 KDa.
|
||
Clone |
2A10-B5
|
||
Isotype |
IgG2a kappa
|
||
GeneID |
|||
UniProt ID |
|||
Summary |
Tryptases comprise a family of trypsin-like serine proteases, the peptidase family S1. Tryptases are enzymatically active only as heparin-stabilized tetramers, and they are resistant to all known endogenous proteinase inhibitors. Several tryptase genes are clustered on chromosome 16p13.3. These genes are characterized by several distinct features. They have a highly conserved 3' UTR and contain tandem repeat sequences at the 5' flank and 3' UTR which are thought to play a role in regulation of the mRNA stability. These genes have an intron immediately upstream of the initiator Met codon, which separates the site of transcription initiation from protein coding sequence. This feature is characteristic of tryptases but is unusual in other genes. The alleles of this gene exhibit an unusual amount of sequence variation, such that the alleles were once thought to represent two separate genes, alpha and beta 1. Beta tryptases appear to be the main isoenzymes expressed in mast cells; whereas in basophils, alpha tryptases predominate. Tryptases have been implicated as mediators in the pathogenesis of asthma and other allergic and inflammatory disorders.
|
||
Form |
Clear, colorless solution in phosphate buffered saline, pH 7.2 . |
||
Storage & Stability |
Store at +4°C short term. For long-term storage, aliquot and store at -20°C or below. Stable for 12 months at -20°C. Avoid repeated freeze-thaw cycles.
|
||
Applications |
WB, IHC, E
|
||
Dilution |
WB~~1:500~1000
|
||
Synonyms |
Tryptase alpha/beta-1, Tryptase-1, Tryptase I, Tryptase alpha-1, TPSAB1, TPS1, TPS2, TPSB1
|
||
Images |

Antibody Reactive Against Recombinant Protein.Western Blot detection against Immunogen (55.99 KDa) . 
TPSAB1 monoclonal antibody (M01), clone 2A10-B5. Western Blot analysis of TPSAB1 expression in K-562.
Immunoperoxidase of monoclonal antibody to TPSAB1 on formalin-fixed paraffin-embedded human lymph node. [antibody concentration 1 ug/ml] |
||
Specification |
|||
Quantity |
|
||
| Select | Brand | Catalog No. | Product Name | Pack Size | Type | Field of Research | Specification | Quantity | Price(USD) | |
| 1 | Leading Biology | APG02467G | CCK4 / PTK7 Antibody (clone 4F9) | 50 μl | Monoclonal Antibodies |
|
$495.00 | Add Ask | ||
| 2 | Leading Biology | AMM04683G | GALT Antibody (clone 4C11) | 50 μg | Monoclonal Antibodies |
|
$545.00 | Add Ask | ||
| 3 | Leading Biology | AMM01402G | Vimentin (Mesenchymal Cell Marker) Antibody - With BSA and Azide | 50 ug | Monoclonal Antibodies |
|
$395.00 | Add Ask | ||
| 4 | Leading Biology | APR08280G | LTA4H / LTA4 Antibody (clone 9G8) | 50 μl | Monoclonal Antibodies |
|
$495.00 | Add Ask | ||
| 5 | Leading Biology | AMM00172G | CD1a / HTA1 (Mature Langerhans Cells Marker) Antibody - With BSA and Azide | 50 ug | Monoclonal Antibodies |
|
$395.00 | Add Ask | ||
| 6 | Leading Biology | AMM05750G | CEBPA Antibody | 100 μl | Monoclonal Antibodies |
|
$545.00 | Add Ask |
 Leading Biology Inc.
2600 Hilltop DR, Building G, B Suite C138
Richmond, CA, 94806
Tel: 1-661-524(LBI)-0262
Email: info@leadingbiology.com
Leading Biology Inc.
2600 Hilltop DR, Building G, B Suite C138
Richmond, CA, 94806
Tel: 1-661-524(LBI)-0262
Email: info@leadingbiology.com
Complete this form and click send to ask us a question, request a quote or simply say hello.

You have 0 item in your cart

You have 0 item in your inquiry list
